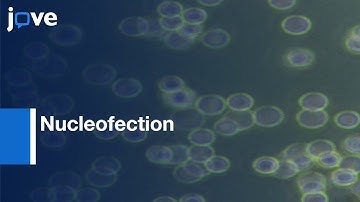

⬇ DOWNLOAD NOW
Kalau muncul iklan pop-up, tutup lalu klik tombol kembali
Download lagu Leukemia Cell line for Macrophage Differentiation and Polarization | Protocol Preview secara gratis hanya untuk keperluan promosi. Dukung artis favorit kamu dengan membeli musik original di iTunes atau platform resmi lainnya.
 Macrophage Polarization and Differentiation Heterogeneity Study | Protocol Preview
Macrophage Polarization and Differentiation Heterogeneity Study | Protocol Preview
 Macrophage Subtypes: Polarization, Activation and Plasticity
Macrophage Subtypes: Polarization, Activation and Plasticity
 M-CSF Differentiated Monocyte-derived Macrophages | Protocol Preview
M-CSF Differentiated Monocyte-derived Macrophages | Protocol Preview
 Advances and Challenges for Understanding Macrophages in the Tumor Microenvironment
Advances and Challenges for Understanding Macrophages in the Tumor Microenvironment
Nucleofection for Efficient Transfection of Human THP-1 Macrophages | Protocol Preview
Nucleofection for Efficient Transfection of Human THP-1 Macrophages | Protocol Preview
 Macrophage engulfs foreign cells
Macrophage engulfs foreign cells
 Leukemia Cells Metabolic Profile Assessment | Protocol Preview
Leukemia Cells Metabolic Profile Assessment | Protocol Preview
 Macrophage Polarization Study by Bone Marrow Derived Macrophages |Protocol Preview
Macrophage Polarization Study by Bone Marrow Derived Macrophages |Protocol Preview